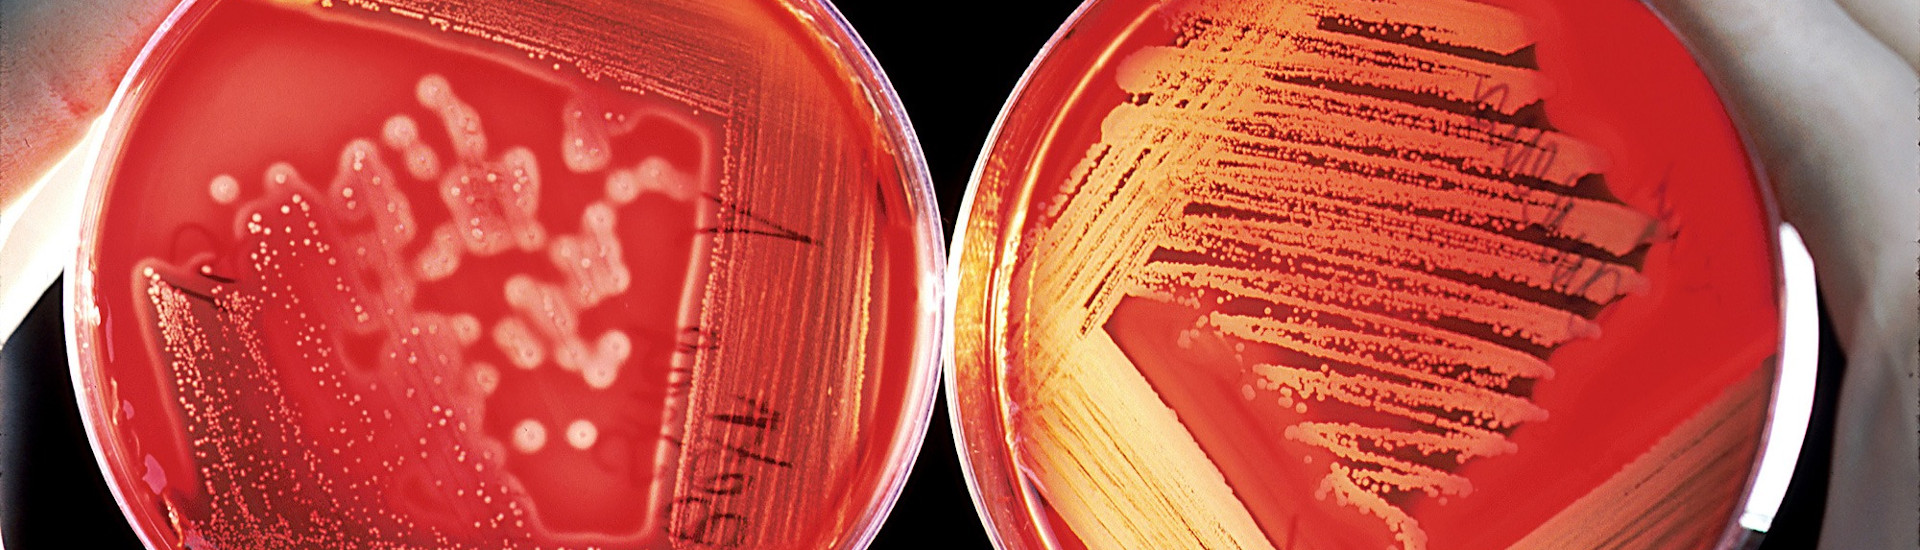

Sanificazione nel settore alimentare
Una corretta sanificazione determina superfici privi di contaminanti fisici, chimici e biologici.
Nella gestione del settore alimentare è un processo fondamentale che va eseguito secondo fasi essenziali:
- Rimozione dello sporco grossolano
- Detersione: per eliminare quello sporco che rimanendo sulle superfici costituisce un buon terreno per i microrganismi
- Risciacquo: per lasciare una superficie pronta all'azione del disinfettante
- Disinfezione: per eliminare i microrganismi rimasti sulla superficie
- Secondo risciacquo: per rimuovere eventuali residui chimici dei prodotti usati
- Asciugatura: per evitare che l'acqua rimasta sulla superficie sia un rischio biologico
Una superficie sanificata è sicuramente una superficie pulita, ma può ospitare ancora contaminazione biologica come quella rappresentata dai batteri.
Distruggere tutti i microrganismi sarebbe un ottimo obiettivo ma è generalmente irrealizzabile per i limiti imposti dalla stessa natura delle operazioni di produzione degli alimenti e dalla natura dei contaminanti biologici. In genere un buon risultato è quello di mantenere a livelli accettabilmente bassi la carica batterica ambientale.
Per molti Operatori, la sanificazione è vista al pari della pulizia che viene fatta nelle nostre case per garantire un livello minimo di igiene, ma non è sufficiente nella gestione del settore alimentare.
Un professionista necessita di formazione anche in questo campo per conosce bene i mezzi usati, le caratteristiche dell'ambiente e dello sporco da eliminare e ottenere così una buona conoscenza dei metodi con cui eliminarlo.
Saturno Laboratorio effettua verifiche di efficacia sanificazione tramite analisi di superficie, stilandone le procedure, oltre a corsi di formazione specifici.